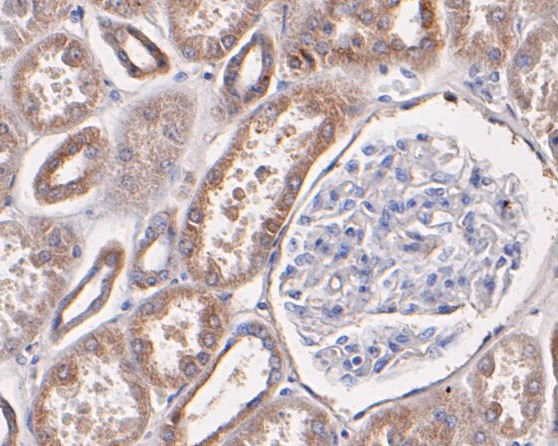
P2X7 Antibody in Immunohistochemistry (Paraffin) (IHC (P))

Search
Huabio
P2X7 Polyclonal Antibody
{{$productOrderCtrl.translations['antibody.pdp.commerceCard.promotion.promotions']}}
{{$productOrderCtrl.translations['antibody.pdp.commerceCard.promotion.viewpromo']}}
{{$productOrderCtrl.translations['antibody.pdp.commerceCard.promotion.promocode']}}: {{promo.promoCode}} {{promo.promoTitle}} {{promo.promoDescription}}. {{$productOrderCtrl.translations['antibody.pdp.commerceCard.promotion.learnmore']}}
图: 1 / 5
P2X7 Antibody (ER1901-99) in IHC (P)





产品信息
ER1901-99
种属反应
宿主/亚型
分类
类型
抗原
偶联物
形式
浓度
规格
纯化类型
保存液
内含物
保存条件
运输条件
靶标信息
The product of this gene belongs to the family of purinoceptors for ATP. This receptor functions as a ligand-gated ion channel and is responsible for ATP-dependent lysis of macrophages through the formation of membrane pores permeable to large molecules. Activation of this nuclear receptor by ATP in the cytoplasm may be a mechanism by which cellular activity can be coupled to changes in gene expression. Multiple alternatively spliced variants have been identified, most of which fit nonsense-mediated decay criteria.
仅用于科研。不用于诊断过程。未经明确授权不得转售。
篇参考文献 (0)
生物信息学
蛋白别名: ATP agonist non-selective cationic pore-forming protein; ATP receptor; ligand gated ion channel; MGC20089; P2X purinoceptor 7; p2X receptor 7; P2X7; P2X7 purinoceptor; P2X7 receptor; P2X7; cervical cancer susceptibility protein; P2Z; P2Z receptor; Purinergic receptor; purinergic receptor P2X, ligand gated ion channel, 7; purinergic receptor P2X7; purnergic receptor P2X 7; unnamed protein product
基因别名: AI467586; P2RX7; P2X(7); P2X7; P2X7R
UniProt ID: (Human) Q99572, (Rat) Q64663, (Mouse) Q9Z1M0
Entrez Gene ID: (Human) 5027, (Rat) 29665, (Mouse) 18439